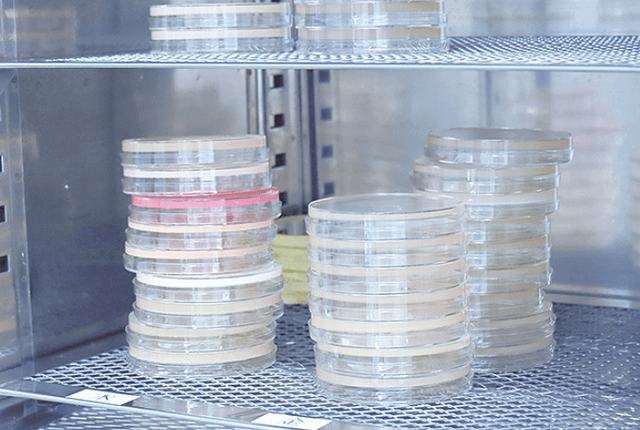
BH型粘度計

Quality Contro
品質管理
日常で長く使われる製品だからこそ、徹底した品質管理を
お客様の信頼に応える
ーエフシー・クオリティ
化粧品に求められる安全性と品質を守る
厳格な検査体制
無農薬素材へのこだわりと、
新鮮で高品質な原料の調達体制


多彩な検査設備で品質を見極める

BH型粘度計

電子天秤

ガラス電極pH計

分光光度計

高速液体クロマトグラフィー(HPLC)
クリーンベンチ
製造ラインにも徹底した品質チェック


原料から製品までの一貫管理


よくある質問
ISO22716について教えてください。
化粧品開発時の試験にはどのようなものがありますか?
お問い合わせ
まずはお気軽にご相談ください